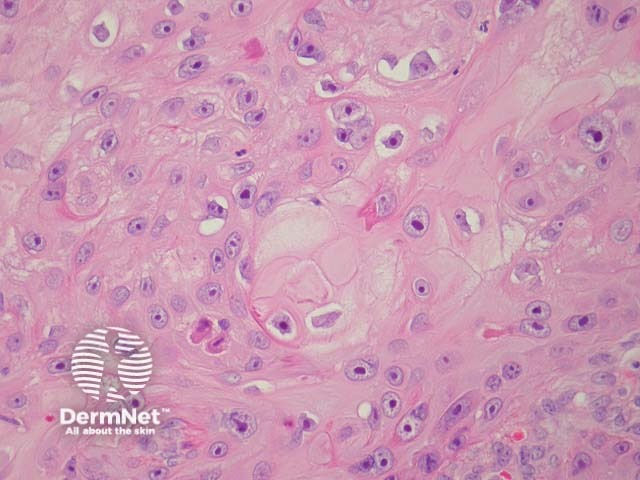
Figure 2
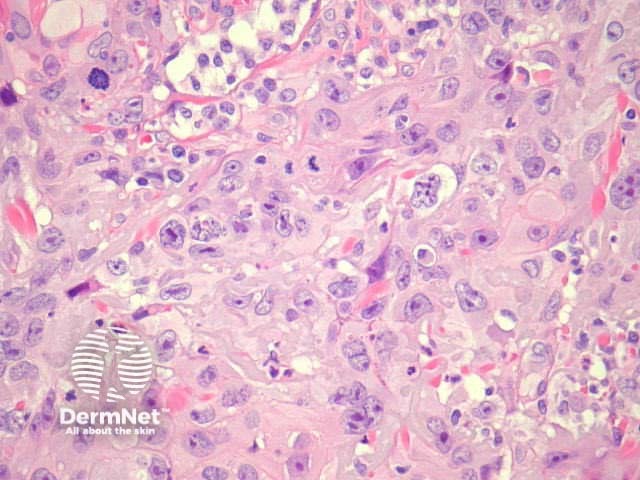
Figure 8

Main menu
Common skin conditions
NEWS
Join DermNet PRO
Read more
Quick links
Author: Dr Nicholas Turnbull, Dermatopathology Fellow, Warwick, UK; A/Prof Patrick Emanual Dermatopathologist, Auckland, New Zealand. 3 May 2014.
Squamous cell carcinoma (SCC) is common form of keratinocytic skin cancer, usually related to exposure to ultraviolet radiation from sunlight. It often arises within solar/actinic keratosis or within squamous cell carcinoma in situ.
Typical SCC has nests of squamous epithelial cells arising from the epidermis and extending into the dermis (figure 1). The malignant cells are often large with abundant eosinophilic cytoplasm and a large, often vesicular, nucleus. Variable keratinisation (keratin pearls etc) is present (figure 2).

Figure 1
Figure 2
Typically SCC is graded as:
Grading of SCC depends on how easy it is to recognise the characteristics of squamous epithelium (eg. intracellular bridges, keratinisation), pleomorphism and mitotic activity. There is considerable inter-observer variation in grading SCC.

Figure 3

Figure 4

Figure 5

Figure 6

Figure 7
Figure 8
SCC can infiltrate along nerve sheaths, adventitia of blood vessels and lymphatics. Inflammation around these structures may be a clue to tumour in these areas. Tumour cells may evoke a stromal desmoplastic response. Extra-tumoural vascular invasion and neural invasion may be seen (figures 9, small – arrow indicates nerve; 10, large).

Figure 9

Figure 10
Spindle cell SCC
Not uncommon. It occurs in sun exposed areas and is associated with a good prognosis. Less commonly spindle cell SCC occurs after ionizing radiation, trauma or sometimes in organ transplant patients. These have worse prognosis (figures 11,12). |
|
|
||
Clear cell SCC
Clear cells containing glycogen are seen in a variable proportions of this tumour. A signet ring SCC is a variant demonstrating clear cells with glycogen compressing and displacing the nucleus laterally (figures 13, 14). |
|
|
||
Desmoplastic SCC
High risk of local recurrence and metastases. Nests and strands surrounded by an intense desmoplastic stromal reaction. Cellular pleomorphism and perineural invasion are frequent features. By definition 1/3 of the tumour should be desmoplastic (figures 15, 16). |
|
|
||
Verrucous carcinoma
High recurrence rate but metastases are rare (except anogenital lesions, which may be related to HPV). Exo-endophytic lesions with bulbous profile and pushing margins. Pleomorphism and mitotic activity is usually minimal and peripheral(figures 17, 18; 18 (B) shows HPV effect). |
|
|
||
Follicular SCC
Frequently found on the head and neck. Develop in the upper part of the hair follicles (figures 19, 20, 21). |
|
|
|
|
Keratoacanthoma-like SCC
Some consider keratoacanthoma (KA) within the spectrum of well differentiated SCC. This subtype is somewhat controversial (figures 22, 23, 24). |
|
|
|
|
Acantholytic SCC
Uncommon variant (2-4%). Central acantholysis leading to an impression of gland formation (figures 25, 26). |
|
|
||
Pseudovascular SCC
Tends to affect men again in sun exposed sites. Recurrence and metastatic rate is high as is mortality. Rare as a primary skin SCC (figure 27). |
|
|||
Adenosquamous carcinoma/ mucoepidermoid carcinoma of the skin
Cutaneous SCC with glandular differentiation is rare. The head and neck are almost exclusively affected. Glandular differentiation may be sparse (figures 28, 29). |
|
|
||
Metaplastic SCC (carcinosarcoma, carcinoma with heterologous differentiation)
Exceedingly rare. This is a biphasic tumour with malignant epithelial (SCC, BCC or adnexal malignancy) and mesenchymal components (figures 30, 31). |
|
|
||
Inflammatory SCC
Dense lymphocytic stromal infiltrate surrounding poorly differentiated squamous nests. This SCC has high metastatic potential (figures 32, 33). |
|
|
||
Basaloid SCC
Found in the oropharynx and anogenital region. High association with HPV infection in anogenital lesions. Small basaloid cells with a high mitotic rate (figures 34, 35) |
|
|
||
Infiltrative SCC
Small nests and strands or single cells infiltrating a dermis which is fibrous and/or mucinous (figure 36). |
|
|||
Pigmented SCC
Melanin is found in epithelial tumour cells as well as in macrophages and dendritic melanocytes. This variant must be distinguished from the squamomelanocytic tumour, in which both a squamous cell carcinoma and melanoma components may occur. |
||||
Pseudohyperplastic SCC
Non-verruciform lesion that occurs on the penis. Associated with lichen sclerosus. Well-differentiated keratinizing nests of squamous cells with minimal atypia surrounded by a reactive fibrous stroma. |
||||
Immunoperoxidase staining may be helpful in poorly differentiated and spindle cell-type SCC. EMA, MNF116, cytokeratin5/6 and p63 are expressed in SCC.
SCC is usually not difficult to recognize pathologically. Deciding if the lesion is invasive or in situ can be more difficult, requiring levels through the specimen to be examined. Benign epithelial changes seen in the context of ulceration, stasis changes or infection can mimic SCC including:
Other tumours may resemble SCC eg keratoacanthoma.
The differential diagnosis of SCC variants can be extensive.